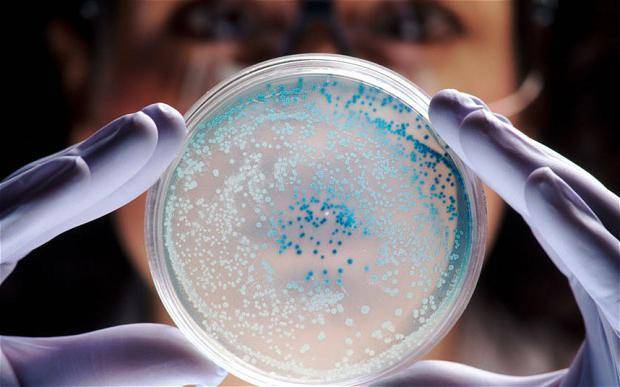
Урок биологии в 6 классе "распространение бактерий. значение бактерий в природе и жизни человека"

Презентация на тему: » Цели: 1. Изучить особенности строения и жизнедеятельности бактерий. 2. Рассмотреть примитивный уровень их организации. 3. Показать роль бактерий в природе.» — Транскрипт:
2
Цели: 1. Изучить особенности строения и жизнедеятельности бактерий. 2. Рассмотреть примитивный уровень их организации. 3. Показать роль бактерий в природе и жизни человека.
3
Формы бактерий. кокки бациллы вибрионы спириллы
4
Строение бактерий. Бактерии – одноклеточные просто организованные доядерные организмы…\ \Scan10095.JPG
5
Распространение бактерий. В 1 г. почвы содержится от 500 млн. до 2 млрд. бактерий, в 1 см молока – 1 млрд., в 1 м воздуха (луг, поле) – 100 бактерий, (город) – 10 – 25 тыс. бактерий летом и 4,5 тыс. зимой
6
Почему бактерии – одноклеточные просто устроенные существа – существуют в природе наряду с высокоорганизованными? Почему бактерии широко распространены в природе?
7
Размножение.
8
Образование спор. Споры бактерий – это приспособление к выживанию в неблагоприятных условиях.
9
Выживанию бактерий способствует: 1) большая скорость размножения при благоприятных условиях; 2) образование спор.
10
Питание. Бактерии (по способу питания) питаются готовыми создают органическими в – ми органические в – ва сапрофиты паразиты.
11
Роль бактерий в природе. Сапрофитные бактерии гниения (участники круговорота веществ в природе, санитары природы). Почвенные бактерии. Азотофиксирующие бактерии. Клубеньковые бактерии.
12
Симбиоз – полезная связь между организмами.
13
Роль бактерий в жизни человека. Молочнокислые бактерии(продукты питания). Сапрофитные бактерии гниения(портят продукты питания, книги, рыболовные сети и т. д.).
14
Бактерии и продукты питания.
15
Болезнетворные бактерии. Болезни: тиф, холера, дифтерия, столбняк, туберкулез, ангина, менингит, сап, сибирская язва, бруцеллез и др.
16
Пути заражения: переносчики возбудителей – блохи, мыши, крысы; при контакте с больным; употребление зараженной пищи, воды; несоблюдение правил личной гигиены.
17
Меры борьбы: 1) соблюдение правил личной гигиены, поддержание чистоты в помещении; 2) контроль за источниками воды и пищевыми продуктами; 3) предупредительные прививки; 4) лекарственные препараты; 5) дезинфекция.
18
Болезни растений. Пятнистость листьев, увядание, гниение стеблей и др.
19
Вопросы. 1. Почему бактерии относятся к доядерным организмам? 2. Чем отличается бактериальная клетка от растительной? 3. Какие бактерии называются сапрофитамия, какие – паразитами? 4. Как бактерии размножаются? 5. Что такое спора в жизни бактерий?
20
Вопросы. 6) Почему без деятельности бактерий жизнь на Земле была бы невозможна? 7)Что вы знаете о клубеньковых бактериях? 8) Что такое симбиоз? 9) Как человек использует молочнокислые бактерии? 10) Какие болезни, вызываемые бактериями, вам известны? 11) Какие меры применяют для борьбы с болезнями?
Врачи отмечают, что изучение бактерий в школе играет важную роль в формировании у детей осознанного отношения к здоровью и окружающей среде. Понимание процессов распространения бактерий помогает ученикам осознать, как микробы влияют на экосистему и здоровье человека. Врачи подчеркивают, что многие бактерии являются жизненно важными для поддержания баланса в природе, участвуя в разложении органических веществ и образовании почвы.
Кроме того, знания о полезных и вредных бактериях могут способствовать формированию у детей привычек, направленных на соблюдение гигиены и профилактику заболеваний. Врачи считают, что подобные уроки способствуют развитию критического мышления и ответственности у школьников, что в будущем может снизить риск инфекционных заболеваний и повысить общий уровень здоровья населения.

Распространение микроорганизмов в природе
Вследствие малых размеров, а также способности усваивать самые разнообразные вещества в качестве источников питания и легко приспосабливаться к условиям внешней среды микроорганизмы широко распространены в природе и могут быть обнаружены там, где отсутствуют другие формы жизни. Широкое распространение микроорганизмов обусловлено также их способностью переносить неблагоприятные условия в виде покоящихся форм, быстро и интенсивно размножаться, переноситься на значительные расстояния водными и воздушными течениями с помощью птиц и насекомых.
Естественной средой обитания микроорганизмов являются почва, вода и организмы человека и животных. Воздух не является благоприятной средой для развития микробов, поскольку не содержит капельно-жидкой воды, но, попадая в воздух с поверхности земли или предметов вместе с пылью, многие микроорганизмы могут временно сохранять жизнеспособность.
Численность и видовой состав микроорганизмов, населяющих почву, определяются наличием в ней влаги и пита- * тельных веществ, реакцией среды, температурой, степенью аэрации. Почва, кроме самого верхнего слоя, служит микроорганизмам защитой от губительною действия прямых солнечных лучей. Почва является местом обитания разнообразных видов бактерий, водорослей, грибов, простейших. Наиболее богаты микроорганизмами хорошо обработанные почвы. Число бактерий в 1 г почвы может составлять несколько миллионов, водорослей ‘— до 100 тыс., грибов — десятки тысяч.
Микроорганизмы, населяющие почву, обладают колоссальной общей поверхностью. Так, в пахотном слое 1 га почв поверхность микробных клеток составляет около 500 га. Именно этим и объясняется чрезвычайно активное воздействие микроорганизмов на почву. Большинство бактерий развивается в верхнем слое почвы глубиной 15 —20 см. Водоросли развиваются в слое до 10 см и иногда вызывают обильное цветение почвы. Выделяя кислород в процессе жизнедеятельности, они способствуют аэрации почвы. В условиях хорошей аэрации верхнего слоя интенсивно развиваются микроскопические грибы. В почве широко представлены черви и личинки насекомых, которые рыхлят почву, обеспечивая проникание кислорода в более глубокие слои.
Микронаселение водных объектов, его численность и видовое разнообразие определяются прежде всего степенью загрязненности воды, т.е. наличием в ней органических веществ. Гидробионты — обитатели волной среды — относятся к различным систематическим группам. В природных водоемах могут развиваться водоросли, бактерии, простейшие, грибы.
Наиболее богаты микроорганизмами сточные воды. Число бактерий в 1 мл сточной воды может превышать 1 млрд. Источником микроорганизмов бытовых сточных вод являются физиологические выделения человека и его хозяйственная деятельность. Некоторые виды производственных сточных вод содержат специфические микроорганизмы, используемые в технологическом процессе производства лекарственных препаратов, спирта, молочнокислых продуктов и т.д. Ливневые сточные воды загрязнены микробами, вымываемыми из почвы.
Значительное число видов микроорганизмов обитает в организме человека и животных. Большинство из них составляет нормальную микрофлору, постоянно обитающую в теле биологического хозяина. Однако многие виды бактерий, простейших, грибов, попадая в организм человека, могут вызвать различные заболевания, такие микроорганизмы называются болезнетворными, или патогенными.
Открытие и изучение
Достаточно долгое время ученые даже не подозревали о существовании организмов, которые были им не видны. Разумеется, первооткрывателем бактерий в XVII веке стал человек, который изобрел микроскоп — уроженец Голландии Антоний ван Левенгук. Его приборы давали увеличение до 160 раз, так что ученый заметил в каплях воды, тине, зубном налете и многих других средах странных существ — он назвал их анималькулями. В ходе исследований ему попадались как разные, так и похожие организмы, и он тщательно зарисовывал их. Так были заложены основы микробиологии. Само же название «бактерии» было предложено Христианом Эренбергом в 1828 году.
О связи этих организмов с различными заболеваниями впервые в конце XVIII века заявил военный врач Д. С. Самойлович. С помощью микроскопа он пытался найти возбудителя чумы, с которой ему пришлось столкнуться во время эпидемии в Москве. Несмотря на то что ему это не удалось, он доказал, что заражение происходит лишь при непосредственном контакте с больным или его вещами. Тогда же и была предложена идея прививок посредством ослабленных или убитых микроорганизмов. Позднее она была реализована в Англии, когда врач Эдуард Дженнер заметил невосприимчивость пациентов к натуральной оспе после коровьей в анамнезе.
Далее в течение нескольких десятилетий микробиология занималась в основном сбором и систематизацией информации, выявляла роль бактерий в природе и различных жизненных процессах. Далее произошло разграничение их с вирусами из-за серьезных различий в строении. Но положительное значение бактерий в жизни природы было оценено далеко не сразу.
Урок биологии в 6 классе о бактериях вызывает живой интерес у школьников. Многие отмечают, что тема оказывается неожиданно увлекательной, ведь бактерии — это не только микроскопические организмы, но и важные участники экосистемы. Учителя стараются сделать занятия интерактивными, используя эксперименты и наглядные примеры.
Ученики обсуждают, как бактерии помогают в пищеварении, участвуют в разложении органических веществ и даже производят кислород. Некоторые ребята удивляются, узнав, что существуют как полезные, так и вредные бактерии. Это открытие побуждает их задуматься о значении микробов в повседневной жизни.
К тому же, уроки о бактериях часто становятся основой для дальнейших исследований и проектов, что вдохновляет детей на изучение биологии в более глубоком формате. В целом, уроки о бактериях формируют у школьников понимание важности этих организмов и их роли в природе и жизни человека.

Особенности
В связи с необходимостью адаптации для выживания в самых разных условиях бактериям приходится не только обладать способностью к быстрому размножению, но и отличаться некоторым разнообразием, о котором речь пойдет чуть позже.
Все организмы, относящиеся к этому царству, разумеется, имеют общие черты. Например, все они являются прокариотами, то есть не имеют отдельного ядра и некоторых других клеточных органелл. Между тем, по размеру они, как правило, более крупные, чем эукариоты, и достигают примерно 0,005 миллиметров. Самая большая известная науке бактерия не превышает 0,75 мм в поперечнике, при этом ее даже можно рассмотреть невооруженным глазом.
Прежде всего представители этого царства имеют клеточную стенку, придающую клетке форму, а также специальную слизистую капсулу, предохраняющую организм от высыхания и способствующую его скользящему движению. Иногда толщина этого слоя может быть больше, чем у остальной части бактерии. Цитоплазма, по сравнению с клетками других микроорганизмов, более густая и структурированная. Все питательные вещества располагаются прямо в ней, поскольку вакуоли отсутствуют. Еще один орган, помогающий клетке двигаться, может быть представлен ворсинками на ее поверхности. Но они могут и отсутствовать.
Значение и роль
Важность того, что делают эти крошечные организмы, сложно переоценить. Роль бактерий в природе поистине огромна
Прежде всего, именно им мы обязаны существованием сложных форм жизни в их нынешнем виде. Ведь сине-зеленые водоросли, как часто называют цианобактерии, фактически создали атмосферу и поддерживают уровень кислорода на необходимом уровне. До сих пор эти микроорганизмы, обитающие в толще мирового океана, генерируют более половины О2.
Пожалуй, второе по важности значение бактерий в природе — это их участие в утилизации органики. Без этого также сложно представить современный мир
Существует целый класс организмов-сапрофитов (куда входят и бактерии). Они непосредственно участвуют в круговороте веществ в природе, разлагая остатки органических тканей до минеральных веществ, необходимых для питания растений. Так что эти «крошки» являются неотъемлемой частью любой экосистемы.
Еще одна важная роль бактерий в природе заключается в преобразовании одних веществ в другие, хоть это не всегда желательно. Дрожжи позволяют получать тесто и алкоголь, а молочнокислые бактерии — кефир, творог, простоквашу и другие подобные продукты. Но и то еще не все. Вспомните о бактериях, составляющих микрофлору кишечника у млекопитающих. Именно они позволяют пищеварительной системе столь эффективно усваивать полезные вещества, поступающие в организм вместе с пищей.

Микрофлора воздуха
В воздушную среду микроорганизмы попадают с поверхности почвы, предметов вместе с пылью и с мельчайшими капельками влаги, сдуваемыми с поверхности водоемов. Микроорганизмы вместе с пылью находятся в воздухе во взвешенном состоянии и могут переноситься на большие расстояния.
В воздухе микробы не могут размножаться, на многие из них губительно действуют недостаток влаги и солнечный свет. Однако они могут временно сохранять в воздухе жизнеспособность.
Микрофлора воздуха не является постоянной, она меняется в зависимости от микрофлоры поверхности данного участка земли, климатических условий, времени года и других факторов. Чем больше в воздух попадает пыли с поверхности земли, тем больше в нем микробов. Зимой в воздухе микробов гораздо меньше, чем летом. Ветер, движение транспорта способствуют увеличению количества микробов в воздухе, выпадающие осадки (снег, дождь) очищают его от микроорганизмов.
Микрофлора воздуха чаще всего состоит из микрококков, сарцин, спор бактерий и плесневых грибов, дрожжей. В воздухе могут находиться и болезнетворные микроорганизмы, например туберкулезные и дифтерийные палочки, коагулазоположительные стафилококки и др.
Воздух скотных дворов при плохом санитарном состоянии может быть загрязнен микрофлорой, содержащейся в навозе и кормах. Во избежание попадания этой микрофлоры в молоко в процессе доения раздачу кормов, чистку животных и уборку помещений производят до доения.
Значительное загрязнение молока и молочных продуктов может быть вызвано мухами. На теле одной мухи находится до 1,5 млн. микробов, среди них преимущественно бактерии группы кишечной палочки, могут быть также болезнетворные (из туалетов).
В воздухе предприятий молочной промышленности обычно преобладают молочнокислые бактерии, дрожжи, бактерии группы кишечной палочки, попадающие туда при разбрызгивании и высыхании молока. Кроме того, в цехах, вырабатывающих сыр, творог, в воздухе часто обнаруживают бактериофаг, попадающий в него при разбрызгивании сыворотки. В воздухе сырохранилищ и холодильных камер чаще всего обнаруживаются плесени.
Для снижения запыленности воздуха в производственных помещениях производят влажную уборку, разбрызгивание раствора хлорной извести, облучение бактерицидными лампами, осуществляют мероприятия по борьбе с мухами.
Микрофлора кормов
В высушенном сене приостанавливаются все микробиологические процессы, многие микробы постепенно вымирают в процессе хранения, преобладающей микрофлорой сена становятся споровые палочки (их споры). Поэтому сухие корма, особенно содержащие много пылевидных частиц, являются источником обсеменения молока споровыми палочками.
В основе процесса приготовления силоса лежит молочнокислое брожение, происходящее в силосной массе под влиянием находящихся на растениях молочнокислых бактерий. Накапливающаяся молочная кислота подавляет развитие вредных бактерий и предотвращает порчу силоса. В случаях, когда силос сильно загрязнен частицами почвы и по тем или иным причинам оказывается подавленным молочнокислый процесс, в нем может начаться гниение, плесневение или маслянокислое брожение, приводящее к образованию масляной кислоты. Такой силос плохо поедается животными, при скармливании его маслянокислые бактерии могут попасть в молоко. Для предотвращения порчи силоса при его закладке применяют специальные закваски молочнокислых бактерий.
Распространение бактерий в природе
Распространены везде, особенно в почве. На поверхности частичек грунта образовывают небольшие колонии. Количество бактерий в почве непостоянно, колеблется, по составу – разнообразно (нитрифицирующие, гниения, азотофиксирующие и т. п.). Способствуют процессам почвообразования.
Много бактерий окружают корни растений, их особую зону – ризосферу. Некоторые бактерии вступают в симбиоз с растениями и образуют бактериоризу.
В воду основная масса бактерий попадает из почвы. Меньше всего бактерий в артезианских колодцах и источниках. Наибольшее количество бактерий сосредоточено в верхних слоях водоемов, ближе к берегу. Могут долго сохраняться в воде. При увеличении глубины и отдалении от берега количество бактерий уменьшается. Большое количество бактерий, особенно их спор (около 75 %), в придонном иле, в особенности в верхних слоях, где они могут образовывать пленку. По видовому составу микрофлора воды подобна почве. Есть в воде специфические бактерии. Бактерии способствуют биологическому очищению воды (разрушают различные остатки).
Численность бактерий в воздухе меньшая, чем в почве и воде. Гибнут от ультрафиолетовых лучей. Более устойчивы к ультрафиолетовым лучам окрашенные бактерии и споры. Могут подниматься в воздух вместе с пылью и находиться там продолжительное время, а потом оседать на поверхности. Количество бактерий в воздухе зависит от разных факторов (климата, времени года). Много бактерий в загрязненном воздухе. Чистый воздух над лесами, горами, снежными покровами.
Значение бактерий
Бактерии играют важную роль в круговороте веществ: азота, углерода, серы, железа. Они осуществляют химические преобразования (хемосинтез), которые недоступны ни растениям, ни животным. Бактерии способствуют процессам почвообразования, перерабатывают (минерализуют) остатки организмов.
Некоторые пурпурные и зеленые серобактерии способны к фотосинтезу. Они играют важную роль в процессе круговорота серы, образуют в почве доступные для растений сульфаты. Некоторые процессы, которые вызывают анаэробные бактерии, используют в пищевой промышленности: молочнокислое (получение кисломолочных продуктов, квашение овощей, силосование кормов, выпечка хлеба), пропионовокислое (в молочносыроварном производстве), уксуснокислое (производство уксуса) брожение и т. п. С помощью бактерий получают лекарственные препараты, некоторые химические вещества.
Могут вступать в мутуалистические отношения с организмом хозяина, как кишечная палочка, которая живет в толстом кишечнике человека или бактерии в рубце жвачных животных. Клубеньковые бактерии обогащают растения доступными азотистыми соединениями. Благодаря им растения способны усваивать азот атмосферы.
Целый ряд бактерий являются возбудителями болезней растений, животных и человека.
Классификация живых существ
На протяжении длительного времени не существовало вообще никакой стройной системы, различающей организмы. Однако знаменитый Карл Линней положил основу современной биноминальной классификации, выделив 3 главных, по его мнению, группы: животные, растения и минералы. Он же и предложил термин «царство».
В дальнейшем, по мере развития технологий и получения новых знаний, классификация совершенствовалась, были выделены прокариоты и эукариоты, главным отличием которых друг от друга являлось отсутствие и наличие в клетках ядра. Сегодня выделяют 8 царств, имеющих значительные различия: вирусы, археи, протисты, хромисты, растения, грибы, животные и бактерии. Что касается последних, все мы знаем об их существовании и постоянно с ними сталкиваемся, хоть и не видим. Может показаться даже странным, что они были выделены в отдельное царство природы.
Вопрос-ответ
В чем состоит значение бактерий в природе и в жизни человека?
Жизнь на Земле невозможна без жизнедеятельности бактерий, так как они участвуют в круговороте веществ в природе, являясь редуцентами, осуществляя химические превращения, не доступные ни животным, ни растениям. Одной из сред жизни бактерий являются другие живые организмы, в том числе человек.
Какую роль играют бактерии в природе и жизни человека 5 класс?
Роль бактерий в природе невозможно переоценить. Благодаря сапротрофным бактериям в почве поддерживается необходимое для жизни растений количество минеральных веществ. Бактерии являются обязательным звеном круговорота веществ в природе. В почве находится огромное количество бактерий разных видов.
Для чего нужны бактерии в жизни человека?
Все эти микроорганизмы выполняют важнейшие функции: участвуют в переработке поступающей пищи, способствуют образованию витаминов К и группы В, подавляют рост патогенов в организме, препятствуют развитию воспалительных процессов, стабилизируют уровень сахара в крови и процессы метаболизма, усиливают защитные силы
Что такое бактерии 6 класс биология?
Бактерии — микроскопические одноклеточные организмы, которых можно встретить везде — в воде, воздухе, почве, на поверхности тел других организмов и даже внутри них. Клетки бактерий окружены прочной оболочкой, но не имеют ядер и сложно устроенных органоидов. Бактерии очень устойчивы к воздействиям внешней среды.
Советы
СОВЕТ №1
Изучайте бактерии с помощью практических экспериментов. Например, вы можете провести простое исследование, используя агаровые пластины для выращивания бактерий из различных источников, таких как рукопожатия или поверхности предметов. Это поможет вам визуализировать разнообразие бактерий и понять их распространение.
СОВЕТ №2
Обратите внимание на роль бактерий в экосистемах. Изучите, как они участвуют в разложении органических веществ и поддержании питательного цикла. Это поможет вам понять, почему бактерии важны не только для человека, но и для природы в целом.
СОВЕТ №3
Не забывайте о значении бактерий для здоровья человека. Исследуйте, как пробиотики и полезные бактерии влияют на пищеварение и иммунную систему. Это знание поможет вам осознанно подходить к выбору продуктов питания и заботиться о своем здоровье.
СОВЕТ №4
Обсуждайте с одноклассниками и учителем актуальные темы, связанные с бактериями, такие как антибиотикорезистентность или использование бактерий в биотехнологиях. Это расширит ваш кругозор и поможет вам лучше понять современное состояние науки о бактериях.















![Распространение микробов в природе [1969 германов н.и. - микробиология]](https://medlari.ru/articles/wp-content/uploads/2024/12/f654db8c9067cdb40420a9905f31012a.jpg)
![Глава 6. распространение микроорганизмов в природе - л. б. богоявленская [1986 черкес ф.к., богоявленская л.б., бельская н.а. - микробиология]](https://medlari.ru/articles/wp-content/uploads/2024/12/2632ed5547fb1edc7bafe37c4d492112.jpg)










































![Распространение микробов в природе [1969 германов н.и. - микробиология]](https://medlari.ru/articles/wp-content/uploads/2024/12/3a20a815d59d37af45754c621119def5.jpg)
![Глава 6. распространение микроорганизмов в природе - л. б. богоявленская [1986 черкес ф.к., богоявленская л.б., бельская н.а. - микробиология]](https://medlari.ru/articles/wp-content/uploads/2024/12/21a53b8ccf5ffb2f13293ebbd35098cc.jpg)